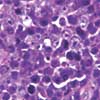

For 2 months, a 30-year-old man with a history of cocaine abuse had had a painful gingival mass and difficulty in eating. Examination revealed a large, fungating mass in the anterior oropharynx that extended posteriorly up to the retromolar region. Posterior cervical lymph nodes were enlarged bilaterally, with no other peripheral lymphadenopathy.

Click to Enlarge
Click to Enlarge
For 2 months, a 30-year-old man with a history of cocaine abuse had had a painful gingival mass (A) and difficulty in eating. Examination revealed a large, fungating mass in the anterior oropharynx that extended posteriorly up to the retromolar region. Posterior cervical lymph nodes were enlarged bilaterally, with no other peripheral lymphadenopathy.
White blood cell count was 2500/µL, with lymphopenia. A CT scan of the head and neck demonstrated extensive soft tissue swelling over the anterior portion of the alveolar ridges and multiple enhancing lymph nodes bilaterally. Chest and abdominal CT findings were unremarkable.
Excision biopsy of the mass showed highly mitotic cells with a focal "starry-sky pattern" and associated tumor necrosis (B). On immunohistochemical staining, the phenotype of the tumor cells was positive for CD138 and CD79a, with high Ki67 activity. Tumor cells demonstrated negative immunoreactivity for CD20. High-grade non-Hodgkin lymphomaplasmablastic lymphoma was diagnosed.
Bone marrow biopsy and aspirate revealed no evidence of tumor involvement. No Epstein-Barr virus (EBV) was detected in the cerebrospinal fluid. An HIV test was positive (CD4+ cell count, 5/µL; viral load greater than 750,000 copies/mL).
Plasmablastic lymphoma is an aggressive type of non-Hodgkin lymphoma with a high proliferation index that is more commonly seen in HIV-positive patients.1
It was initially reported in the late 1990s in the oral cavity and jaws of HIV-infected patients.2 Since then, it has been reported in HIV-negative persons, with involvement of other extranodal sites, such as the gallbladder, large bowel, and stomach.1,2 A lymphoma in an unusual site and the lack of conventional B-cell marker expression should signal the diagnosis in HIV-positive patients.3 These tumors usually have minimal or no expression of CD20.2 The high prevalence of EBV infection in patients with plasmablastic lymphoma suggests an association with the virus.2,4 Plasmablastic lymphoma may be confused with anaplastic plasmacytomas or myeloma; however, it is not associated with serum monoclonal paraprotein or lytic bone lesions.2,4
Cyclophosphamide, doxorubicin, vincristine, and prednisone (CHOP) protocol induces complete remission in 57% of patients.5 HAART is recommended in all HIV-positive patients with plasmablastic lymphoma to increase response.2,4,5 Median survival ranges from a few months to 5 years without disease.
This patient's mass decreased significantly after the first cycle of reduced-dose CHOP chemotherapy and completely resolved by the third cycle. In addition, HAART was started. The patient is currently disease-free and undergoing his last cycle of chemotherapy.
REFERENCES:
1.
Borrero JJ, Pujol E, PŽrez S, et al. Plasmablastic lymphoma of the oral cavity and jaws. AIDS. 2002;16:1979-1980.
2.
Delecluse HJ, Anagnostopoulos I, Dallenbach F, et al. Plasmablastic lymphomas of the oral cavity: a new entity associated with the human immunodeficiency virus infection. Blood. 1997;89:1413-1420.
3.
Chetty R, Hlatswayo N, Muc R, et al. Plasmablastic lymphoma in HIV+ patients: an expanding spectrum. Histopathology. 2003;42:605-609.
4
. Teruya-Feldstein J, Chiao E, Filippa DA, et al. CD20-negative large-cell lymphoma with plasmablastic features: a clinically heterogenous spectrum in both HIV-positive and -negative patients. Ann Oncol. 2004;15:1673-1679.
5.
Hoffmann C, Wolf E, FÅ tkenheuer G, et al. Response to highly active antiretroviral therapy strongly predicts outcome in patients with AIDS-related lymphoma. AIDS. 2003;17:1521-1529.